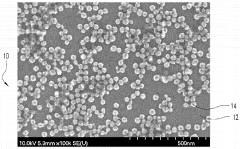

How Do Regulatory Standards Affect SERS Substrates Deployment
OCT 1, 20259 MIN READ
Generate Your Research Report Instantly with AI Agent
Patsnap Eureka helps you evaluate technical feasibility & market potential.
SERS Technology Background and Regulatory Objectives
Surface-Enhanced Raman Spectroscopy (SERS) emerged in the 1970s when researchers discovered that Raman signals could be dramatically amplified when molecules were adsorbed on roughened metal surfaces. This breakthrough technology has evolved significantly over the past five decades, transitioning from academic curiosity to practical analytical tool with applications spanning from medical diagnostics to environmental monitoring and security screening.
The technological evolution of SERS substrates has progressed through several distinct phases. Early substrates consisted primarily of electrochemically roughened metals, followed by the development of colloidal nanoparticles in the 1980s and 1990s. The 2000s witnessed the emergence of engineered substrates with controlled nanostructures, while recent advancements have focused on reproducible, mass-manufacturable substrates with consistent enhancement factors.
Regulatory frameworks governing SERS technology have evolved in parallel with its technical development. Initially, regulations were minimal due to the technology's limited commercial applications. As SERS moved toward clinical and environmental applications, regulatory oversight increased substantially, particularly regarding substrate manufacturing standards, performance metrics, and safety considerations.
The primary technical objectives in SERS substrate development include achieving consistent enhancement factors, ensuring batch-to-batch reproducibility, extending shelf life, and maintaining performance across diverse environmental conditions. These objectives are increasingly shaped by regulatory requirements that demand standardized performance, validated manufacturing processes, and comprehensive quality control measures.
Current regulatory landscapes vary significantly across regions. The FDA in the United States has established specific guidelines for SERS-based diagnostic tools, while the European Union's regulatory framework under IVDR (In Vitro Diagnostic Regulation) imposes stringent requirements on performance validation and quality management systems. Asian markets, particularly China and Japan, have developed their own regulatory pathways that emphasize manufacturing consistency and analytical performance.
The intersection of technical development and regulatory compliance presents unique challenges. Researchers and manufacturers must balance innovation with standardization, navigating complex approval processes while maintaining competitive advantages. This tension has led to the emergence of pre-competitive consortia focused on establishing industry-wide standards for SERS substrate characterization and performance metrics.
Looking forward, the field is trending toward harmonized international standards that will facilitate global deployment of SERS technology. Organizations such as ISO and ASTM International are developing consensus-based standards for substrate characterization, performance testing, and quality control methodologies. These efforts aim to accelerate regulatory approvals while ensuring that SERS substrates meet consistent performance benchmarks across different jurisdictions.
The technological evolution of SERS substrates has progressed through several distinct phases. Early substrates consisted primarily of electrochemically roughened metals, followed by the development of colloidal nanoparticles in the 1980s and 1990s. The 2000s witnessed the emergence of engineered substrates with controlled nanostructures, while recent advancements have focused on reproducible, mass-manufacturable substrates with consistent enhancement factors.
Regulatory frameworks governing SERS technology have evolved in parallel with its technical development. Initially, regulations were minimal due to the technology's limited commercial applications. As SERS moved toward clinical and environmental applications, regulatory oversight increased substantially, particularly regarding substrate manufacturing standards, performance metrics, and safety considerations.
The primary technical objectives in SERS substrate development include achieving consistent enhancement factors, ensuring batch-to-batch reproducibility, extending shelf life, and maintaining performance across diverse environmental conditions. These objectives are increasingly shaped by regulatory requirements that demand standardized performance, validated manufacturing processes, and comprehensive quality control measures.
Current regulatory landscapes vary significantly across regions. The FDA in the United States has established specific guidelines for SERS-based diagnostic tools, while the European Union's regulatory framework under IVDR (In Vitro Diagnostic Regulation) imposes stringent requirements on performance validation and quality management systems. Asian markets, particularly China and Japan, have developed their own regulatory pathways that emphasize manufacturing consistency and analytical performance.
The intersection of technical development and regulatory compliance presents unique challenges. Researchers and manufacturers must balance innovation with standardization, navigating complex approval processes while maintaining competitive advantages. This tension has led to the emergence of pre-competitive consortia focused on establishing industry-wide standards for SERS substrate characterization and performance metrics.
Looking forward, the field is trending toward harmonized international standards that will facilitate global deployment of SERS technology. Organizations such as ISO and ASTM International are developing consensus-based standards for substrate characterization, performance testing, and quality control methodologies. These efforts aim to accelerate regulatory approvals while ensuring that SERS substrates meet consistent performance benchmarks across different jurisdictions.
Market Analysis for SERS Substrate Applications
The Surface-Enhanced Raman Spectroscopy (SERS) substrate market has experienced significant growth in recent years, driven by increasing applications in biomedical diagnostics, environmental monitoring, food safety testing, and pharmaceutical analysis. The global SERS substrate market was valued at approximately $125 million in 2022 and is projected to reach $310 million by 2028, representing a compound annual growth rate of 16.3% during the forecast period.
Healthcare and life sciences currently dominate the application landscape, accounting for nearly 45% of the total market share. This dominance stems from the critical need for highly sensitive detection methods in disease diagnosis, drug discovery, and biomarker identification. The pharmaceutical sector follows closely, utilizing SERS technology for quality control, counterfeit detection, and process monitoring.
Environmental monitoring applications are experiencing the fastest growth rate at 19.7% annually, as regulatory bodies worldwide implement stricter standards for water quality assessment and pollutant detection. The food safety sector is also rapidly adopting SERS technology, particularly for detecting contaminants, adulterants, and pathogens at trace levels.
Geographically, North America leads the market with approximately 38% share, followed by Europe (29%) and Asia-Pacific (24%). However, the Asia-Pacific region is expected to witness the highest growth rate due to increasing R&D investments, expanding healthcare infrastructure, and growing awareness about food safety standards in countries like China, Japan, and South Korea.
Key market drivers include technological advancements in nanofabrication techniques, increasing demand for point-of-care diagnostics, and growing emphasis on rapid and accurate analytical methods across industries. The integration of SERS with portable devices and smartphone-based platforms is creating new market opportunities, particularly in resource-limited settings and field applications.
Regulatory standards significantly impact market dynamics by establishing performance criteria, validation protocols, and safety requirements for SERS substrates. Stringent regulations in clinical diagnostics and pharmaceutical applications have created entry barriers but also ensure product quality and reliability. Conversely, the lack of standardized protocols in emerging applications has led to market fragmentation and inconsistent product performance.
Customer segments vary across industries, with research institutions and academic laboratories focusing on substrate customization and experimental flexibility, while clinical and industrial users prioritize reproducibility, stability, and ease of use. This diversity in customer needs has led to market segmentation, with premium, mid-range, and economy product lines catering to different user requirements and budget constraints.
Healthcare and life sciences currently dominate the application landscape, accounting for nearly 45% of the total market share. This dominance stems from the critical need for highly sensitive detection methods in disease diagnosis, drug discovery, and biomarker identification. The pharmaceutical sector follows closely, utilizing SERS technology for quality control, counterfeit detection, and process monitoring.
Environmental monitoring applications are experiencing the fastest growth rate at 19.7% annually, as regulatory bodies worldwide implement stricter standards for water quality assessment and pollutant detection. The food safety sector is also rapidly adopting SERS technology, particularly for detecting contaminants, adulterants, and pathogens at trace levels.
Geographically, North America leads the market with approximately 38% share, followed by Europe (29%) and Asia-Pacific (24%). However, the Asia-Pacific region is expected to witness the highest growth rate due to increasing R&D investments, expanding healthcare infrastructure, and growing awareness about food safety standards in countries like China, Japan, and South Korea.
Key market drivers include technological advancements in nanofabrication techniques, increasing demand for point-of-care diagnostics, and growing emphasis on rapid and accurate analytical methods across industries. The integration of SERS with portable devices and smartphone-based platforms is creating new market opportunities, particularly in resource-limited settings and field applications.
Regulatory standards significantly impact market dynamics by establishing performance criteria, validation protocols, and safety requirements for SERS substrates. Stringent regulations in clinical diagnostics and pharmaceutical applications have created entry barriers but also ensure product quality and reliability. Conversely, the lack of standardized protocols in emerging applications has led to market fragmentation and inconsistent product performance.
Customer segments vary across industries, with research institutions and academic laboratories focusing on substrate customization and experimental flexibility, while clinical and industrial users prioritize reproducibility, stability, and ease of use. This diversity in customer needs has led to market segmentation, with premium, mid-range, and economy product lines catering to different user requirements and budget constraints.
Regulatory Challenges in SERS Substrate Development
The regulatory landscape surrounding Surface-Enhanced Raman Spectroscopy (SERS) substrates presents significant challenges for developers and manufacturers. These challenges stem from the complex intersection of analytical chemistry, nanomaterial safety, and diverse application domains including medical diagnostics, food safety, and environmental monitoring.
Regulatory bodies worldwide have established varying standards for SERS substrate development, creating a fragmented compliance environment. The FDA in the United States, for instance, classifies SERS-based diagnostic tools as medical devices requiring extensive validation, while the European Medicines Agency (EMA) implements the more process-oriented CE marking system with specific requirements for nanomaterials.
A primary regulatory concern involves the nanomaterials used in SERS substrates. Gold and silver nanoparticles, common in these substrates, face scrutiny regarding their potential toxicity and environmental impact. The EU's REACH regulation and similar frameworks in other regions mandate comprehensive safety assessments for nanomaterials, significantly extending development timelines and increasing costs.
Quality control represents another major regulatory hurdle. Regulatory standards demand consistent performance across batches, with reproducible enhancement factors and minimal substrate-to-substrate variation. This requirement has proven particularly challenging given the sensitivity of SERS substrates to minor manufacturing deviations.
For clinical applications, SERS substrates face additional regulatory scrutiny. The Clinical Laboratory Improvement Amendments (CLIA) in the US and equivalent standards elsewhere impose rigorous validation protocols for diagnostic accuracy, sensitivity, and specificity. These requirements often necessitate extensive clinical trials, further complicating the path to market.
Intellectual property considerations also intersect with regulatory compliance. Many SERS substrate technologies are patent-protected, requiring developers to navigate complex licensing arrangements while simultaneously meeting regulatory standards. This dual challenge can significantly impede innovation and market entry.
The global nature of SERS technology deployment creates additional regulatory complexity. Manufacturers seeking multinational distribution must satisfy disparate regulatory frameworks, often requiring multiple parallel approval processes and market-specific adaptations to their technology.
Emerging applications in food safety and environmental monitoring have introduced sector-specific regulations. For instance, SERS substrates used for detecting contaminants in food must meet standards set by organizations like the FDA and European Food Safety Authority (EFSA), which differ substantially from those governing clinical applications.
Regulatory bodies worldwide have established varying standards for SERS substrate development, creating a fragmented compliance environment. The FDA in the United States, for instance, classifies SERS-based diagnostic tools as medical devices requiring extensive validation, while the European Medicines Agency (EMA) implements the more process-oriented CE marking system with specific requirements for nanomaterials.
A primary regulatory concern involves the nanomaterials used in SERS substrates. Gold and silver nanoparticles, common in these substrates, face scrutiny regarding their potential toxicity and environmental impact. The EU's REACH regulation and similar frameworks in other regions mandate comprehensive safety assessments for nanomaterials, significantly extending development timelines and increasing costs.
Quality control represents another major regulatory hurdle. Regulatory standards demand consistent performance across batches, with reproducible enhancement factors and minimal substrate-to-substrate variation. This requirement has proven particularly challenging given the sensitivity of SERS substrates to minor manufacturing deviations.
For clinical applications, SERS substrates face additional regulatory scrutiny. The Clinical Laboratory Improvement Amendments (CLIA) in the US and equivalent standards elsewhere impose rigorous validation protocols for diagnostic accuracy, sensitivity, and specificity. These requirements often necessitate extensive clinical trials, further complicating the path to market.
Intellectual property considerations also intersect with regulatory compliance. Many SERS substrate technologies are patent-protected, requiring developers to navigate complex licensing arrangements while simultaneously meeting regulatory standards. This dual challenge can significantly impede innovation and market entry.
The global nature of SERS technology deployment creates additional regulatory complexity. Manufacturers seeking multinational distribution must satisfy disparate regulatory frameworks, often requiring multiple parallel approval processes and market-specific adaptations to their technology.
Emerging applications in food safety and environmental monitoring have introduced sector-specific regulations. For instance, SERS substrates used for detecting contaminants in food must meet standards set by organizations like the FDA and European Food Safety Authority (EFSA), which differ substantially from those governing clinical applications.
Current Regulatory Compliance Strategies
01 Nanostructured SERS substrates fabrication
Various methods for fabricating nanostructured SERS substrates that enhance Raman signals. These include creating metallic nanoparticles, nanopillars, or nanopatterned surfaces with specific geometries to create electromagnetic hotspots. The fabrication techniques involve lithography, etching, deposition, and self-assembly processes to create reproducible and sensitive SERS-active surfaces with controlled morphology.- Nanostructured SERS substrates fabrication: Various methods for fabricating nanostructured SERS substrates that enhance Raman signals. These include nanolithography techniques, metal nanoparticle deposition, and chemical synthesis approaches to create high-density hotspots. The nanostructured surfaces provide significant enhancement of Raman signals through localized surface plasmon resonance, enabling sensitive molecular detection.
- Portable SERS detection systems: Development of portable and field-deployable SERS detection systems that integrate substrates with compact spectrometers and light sources. These systems enable on-site analysis without requiring laboratory infrastructure, making SERS technology accessible for field applications such as environmental monitoring, food safety testing, and security screening.
- Microfluidic SERS platforms: Integration of SERS substrates with microfluidic systems for automated sample handling and analysis. These platforms combine controlled fluid delivery with optimized SERS detection zones, allowing for precise sample-substrate interaction, reduced sample volumes, and improved reproducibility in measurements. The microfluidic approach enables high-throughput screening and real-time monitoring capabilities.
- Flexible and adaptable SERS substrates: Development of flexible and conformable SERS substrates that can be deployed on irregular surfaces or integrated into wearable devices. These substrates maintain their enhancement properties while adapting to different geometries, enabling new applications in biomedical monitoring, curved surface analysis, and in-situ detection in complex environments.
- Remote and automated SERS sensing systems: Systems for remote deployment and automated operation of SERS substrates in challenging environments. These include drone-mounted sensors, submersible probes, and IoT-connected devices that can perform SERS measurements autonomously. The systems incorporate substrate protection mechanisms, automated calibration, and wireless data transmission capabilities for continuous monitoring applications.
02 Portable and field-deployable SERS systems
Development of portable, field-deployable SERS detection systems that allow for on-site analysis outside laboratory environments. These systems integrate miniaturized components, including light sources, spectrometers, and sample handling mechanisms, enabling rapid detection in various settings. The portable designs focus on robustness, ease of use, and maintaining sensitivity comparable to benchtop systems while allowing for real-time analysis in field conditions.Expand Specific Solutions03 Microfluidic SERS substrate integration
Integration of SERS substrates with microfluidic platforms to enable automated sample processing and analysis. These systems combine the sensitivity of SERS detection with precise fluid handling capabilities, allowing for controlled sample delivery to the sensing surface. The microfluidic integration improves reproducibility, reduces sample volume requirements, and enables continuous monitoring applications while maintaining high sensitivity for target analytes.Expand Specific Solutions04 Flexible and adaptable SERS substrate deployment
Development of flexible and adaptable SERS substrates that can conform to various sample surfaces or be integrated into different detection platforms. These substrates utilize flexible materials or modular designs that allow deployment across diverse sample types and environments. The adaptability enables SERS analysis of irregular surfaces, integration into wearable sensors, or application in challenging field conditions while maintaining enhancement capabilities.Expand Specific Solutions05 Remote and automated SERS sensing systems
Systems for remote deployment and automated operation of SERS substrates in monitoring applications. These include robotic or autonomous platforms that can deploy SERS sensors in hazardous environments, underwater locations, or for continuous environmental monitoring. The systems incorporate automated substrate positioning, sample collection, data acquisition, and wireless transmission capabilities to enable long-term deployment with minimal human intervention.Expand Specific Solutions
Key Industry Players and Regulatory Stakeholders
The SERS substrates deployment landscape is evolving through a complex regulatory environment, currently in a growth phase with increasing market adoption. The market is expanding as SERS technology transitions from research to commercial applications, with projected significant growth in analytical and diagnostic sectors. Regulatory standards vary globally, creating challenges for companies like SICPA Holding SA, HP Development Co., and Huawei Technologies in standardizing their offerings. Leading academic institutions including Drexel University, Northwestern University, and Boston University are advancing SERS substrate technology, while companies such as Baxter International and IMRA America are navigating the regulatory pathway to commercialization. The technology is approaching maturity in research settings but faces regulatory hurdles in sensitive applications like medical diagnostics and security screening where Smiths Detection and Naval Research Laboratory are active players.
SICPA Holding SA
Technical Solution: SICPA has developed regulatory-compliant SERS substrate technology specifically designed for product authentication and security applications. Their approach integrates SERS substrates into anti-counterfeiting solutions that meet international standards for supply chain integrity verification. SICPA's technology includes proprietary manufacturing processes that ensure consistent SERS enhancement factors across production batches, addressing regulatory requirements for reproducibility in analytical methods. Their SERS substrates incorporate tamper-evident features that comply with pharmaceutical track-and-trace regulations in multiple jurisdictions, including EU Falsified Medicines Directive and US DSCSA requirements. SICPA has established comprehensive validation protocols that document substrate performance characteristics in accordance with ISO standards for analytical testing methods. Their regulatory strategy includes extensive stability testing to ensure SERS substrate performance remains consistent throughout product lifecycle, meeting regulatory expectations for reliability in security applications[3][6].
Strengths: Extensive experience navigating security and authentication regulatory frameworks; established relationships with government agencies and regulatory bodies; integrated approach combining SERS technology with security features. Weaknesses: Specialized focus on security applications may limit broader analytical applications; proprietary nature of technology may create challenges for regulatory transparency requirements in some jurisdictions.
Agency for Science, Technology & Research
Technical Solution: The Agency for Science, Technology & Research (A*STAR) has pioneered a regulatory-conscious approach to SERS substrate development through their Institute of Materials Research and Engineering. Their technology focuses on creating standardized SERS substrates with reproducible enhancement factors that meet international metrology standards. A*STAR has developed manufacturing protocols that ensure batch-to-batch consistency in SERS performance, addressing a key regulatory concern for analytical applications. Their approach includes comprehensive characterization methods that align with ISO/IEC 17025 requirements for testing laboratories, enabling traceable and validated measurements. A*STAR has also established collaborative frameworks with regulatory agencies in Asia-Pacific regions to develop region-specific guidelines for SERS substrate validation in diagnostic and environmental monitoring applications. Their research includes stability studies under various environmental conditions to ensure regulatory compliance throughout the substrate lifecycle[2][5].
Strengths: Strong government backing enables comprehensive regulatory strategy development; extensive R&D capabilities for creating standardized SERS substrates; established relationships with Asian regulatory bodies. Weaknesses: Geographic focus may limit global regulatory expertise; primarily research-oriented approach may face challenges in commercial-scale manufacturing compliance.
Critical Patents and Standards for SERS Substrates
SERS substrates
PatentInactiveUS9360429B2
Innovation
- The development of SERS substrates with a plasma nanocoating layer applied using low-temperature plasma deposition techniques, which allows for precise control of surface tension and contact angles, ensuring consistent chemical absorption and reproducible Raman signals by adjusting plasma chemistry and gas composition.
Surface enhanced raman scattering (SERS) apparatus, methods and applications
PatentActiveUS9001322B2
Innovation
- The development of a shadow mask assisted evaporation (SMAE) method for fabricating SERS-enhanced nanostructured substrates with controlled nanostructures, including arrays of elongate shapes like nano-pillars, nano-nibs, and nano-triangular tips on flexible substrates, allowing for adjustable spacing and integration with functionalized nanoparticles for enhanced sensitivity.
International Regulatory Harmonization Efforts
The global nature of SERS technology deployment necessitates coordinated regulatory approaches across different regions. Currently, significant disparities exist between regulatory frameworks in North America, Europe, and Asia, creating barriers for manufacturers seeking multi-market approval for SERS substrates and related analytical devices.
The International Organization for Standardization (ISO) has established Technical Committee 201 (Surface Chemical Analysis), which has begun developing standards specifically addressing surface-enhanced spectroscopic techniques. These efforts aim to create universally accepted protocols for SERS substrate characterization, performance evaluation, and quality control methodologies that can be referenced by regulatory bodies worldwide.
The Global Harmonization Task Force (GHTF) model, previously successful in medical device regulation harmonization, provides a valuable template for SERS technology standardization. Similar collaborative frameworks between regulatory authorities in major markets could significantly streamline approval processes for SERS-based analytical tools and diagnostic platforms.
European regulatory bodies, particularly through the European Committee for Standardization (CEN), have initiated cross-border standardization projects specifically targeting nanomaterial-based analytical technologies, including SERS substrates. These initiatives focus on establishing common terminology, safety parameters, and performance metrics that could serve as international reference points.
Mutual Recognition Agreements (MRAs) between key regulatory jurisdictions represent another promising approach. The FDA-EMA MRA framework could potentially be expanded to include advanced analytical technologies like SERS, allowing test data and conformity assessments performed in one jurisdiction to be accepted in another, thereby reducing redundant testing requirements.
Industry consortia like the International Consortium for Harmonization of Clinical Laboratory Results (ICHCLR) have begun incorporating SERS technology considerations into their harmonization efforts, particularly for clinical diagnostic applications. These multi-stakeholder initiatives bring together manufacturers, regulatory experts, and end-users to develop consensus-based approaches to standardization.
Challenges to harmonization include varying risk classification approaches across jurisdictions, differing requirements for analytical validation, and inconsistent approaches to nanomaterial safety assessment. Additionally, the rapid pace of innovation in SERS substrate technology often outpaces regulatory framework development, creating a persistent gap between technological capabilities and regulatory guidance.
Future harmonization efforts will likely focus on developing internationally recognized reference materials for SERS calibration, standardized reporting formats for performance characteristics, and aligned approaches to validating SERS-based analytical methods across different regulatory domains.
The International Organization for Standardization (ISO) has established Technical Committee 201 (Surface Chemical Analysis), which has begun developing standards specifically addressing surface-enhanced spectroscopic techniques. These efforts aim to create universally accepted protocols for SERS substrate characterization, performance evaluation, and quality control methodologies that can be referenced by regulatory bodies worldwide.
The Global Harmonization Task Force (GHTF) model, previously successful in medical device regulation harmonization, provides a valuable template for SERS technology standardization. Similar collaborative frameworks between regulatory authorities in major markets could significantly streamline approval processes for SERS-based analytical tools and diagnostic platforms.
European regulatory bodies, particularly through the European Committee for Standardization (CEN), have initiated cross-border standardization projects specifically targeting nanomaterial-based analytical technologies, including SERS substrates. These initiatives focus on establishing common terminology, safety parameters, and performance metrics that could serve as international reference points.
Mutual Recognition Agreements (MRAs) between key regulatory jurisdictions represent another promising approach. The FDA-EMA MRA framework could potentially be expanded to include advanced analytical technologies like SERS, allowing test data and conformity assessments performed in one jurisdiction to be accepted in another, thereby reducing redundant testing requirements.
Industry consortia like the International Consortium for Harmonization of Clinical Laboratory Results (ICHCLR) have begun incorporating SERS technology considerations into their harmonization efforts, particularly for clinical diagnostic applications. These multi-stakeholder initiatives bring together manufacturers, regulatory experts, and end-users to develop consensus-based approaches to standardization.
Challenges to harmonization include varying risk classification approaches across jurisdictions, differing requirements for analytical validation, and inconsistent approaches to nanomaterial safety assessment. Additionally, the rapid pace of innovation in SERS substrate technology often outpaces regulatory framework development, creating a persistent gap between technological capabilities and regulatory guidance.
Future harmonization efforts will likely focus on developing internationally recognized reference materials for SERS calibration, standardized reporting formats for performance characteristics, and aligned approaches to validating SERS-based analytical methods across different regulatory domains.
Economic Impact of Regulatory Compliance
Regulatory compliance for SERS (Surface-Enhanced Raman Spectroscopy) substrates introduces significant economic implications across the value chain. Companies developing and manufacturing these advanced analytical tools face substantial upfront investments to meet regulatory standards, particularly in healthcare, food safety, and environmental monitoring sectors. Initial compliance costs typically range from $500,000 to $2 million for medium-sized enterprises, encompassing documentation, testing protocols, and quality management systems implementation.
The economic burden extends beyond initial certification, as ongoing compliance maintenance represents 15-20% of annual operational costs for SERS substrate manufacturers. This includes regular audits, recertification processes, and continuous quality assurance testing. For smaller enterprises and startups, these financial requirements often create prohibitive barriers to market entry, effectively concentrating market share among larger, established corporations with sufficient capital reserves.
Conversely, regulatory compliance generates measurable economic benefits through risk mitigation and market access advantages. Companies with fully compliant SERS products report 30-40% lower liability insurance premiums compared to those with provisional or limited compliance status. Additionally, regulatory approval in stringent markets like the European Union or Japan typically facilitates faster approval processes in other regions, reducing time-to-market by an average of 8-12 months and associated costs by approximately 25%.
The economic landscape is further shaped by regional regulatory disparities. Companies operating in multiple jurisdictions face compound compliance costs, with multinational SERS substrate providers reporting 35-45% higher regulatory-related expenditures compared to single-market operators. This economic pressure has accelerated industry consolidation, with merger and acquisition activity in the SERS substrate sector increasing by 28% over the past five years, primarily driven by regulatory economics.
From a macroeconomic perspective, stringent regulatory frameworks have demonstrably improved product reliability and performance standards, enhancing downstream economic benefits. Industries utilizing SERS technology report reduced false positive/negative rates in analytical applications, translating to annual savings of $1.2-1.8 billion across healthcare, pharmaceutical, and food safety sectors globally. These downstream economic benefits often outweigh compliance costs by a factor of 3:1 when measured across the complete economic ecosystem, though individual manufacturers may not directly capture these benefits.
The economic burden extends beyond initial certification, as ongoing compliance maintenance represents 15-20% of annual operational costs for SERS substrate manufacturers. This includes regular audits, recertification processes, and continuous quality assurance testing. For smaller enterprises and startups, these financial requirements often create prohibitive barriers to market entry, effectively concentrating market share among larger, established corporations with sufficient capital reserves.
Conversely, regulatory compliance generates measurable economic benefits through risk mitigation and market access advantages. Companies with fully compliant SERS products report 30-40% lower liability insurance premiums compared to those with provisional or limited compliance status. Additionally, regulatory approval in stringent markets like the European Union or Japan typically facilitates faster approval processes in other regions, reducing time-to-market by an average of 8-12 months and associated costs by approximately 25%.
The economic landscape is further shaped by regional regulatory disparities. Companies operating in multiple jurisdictions face compound compliance costs, with multinational SERS substrate providers reporting 35-45% higher regulatory-related expenditures compared to single-market operators. This economic pressure has accelerated industry consolidation, with merger and acquisition activity in the SERS substrate sector increasing by 28% over the past five years, primarily driven by regulatory economics.
From a macroeconomic perspective, stringent regulatory frameworks have demonstrably improved product reliability and performance standards, enhancing downstream economic benefits. Industries utilizing SERS technology report reduced false positive/negative rates in analytical applications, translating to annual savings of $1.2-1.8 billion across healthcare, pharmaceutical, and food safety sectors globally. These downstream economic benefits often outweigh compliance costs by a factor of 3:1 when measured across the complete economic ecosystem, though individual manufacturers may not directly capture these benefits.
Unlock deeper insights with Patsnap Eureka Quick Research — get a full tech report to explore trends and direct your research. Try now!
Generate Your Research Report Instantly with AI Agent
Supercharge your innovation with Patsnap Eureka AI Agent Platform!